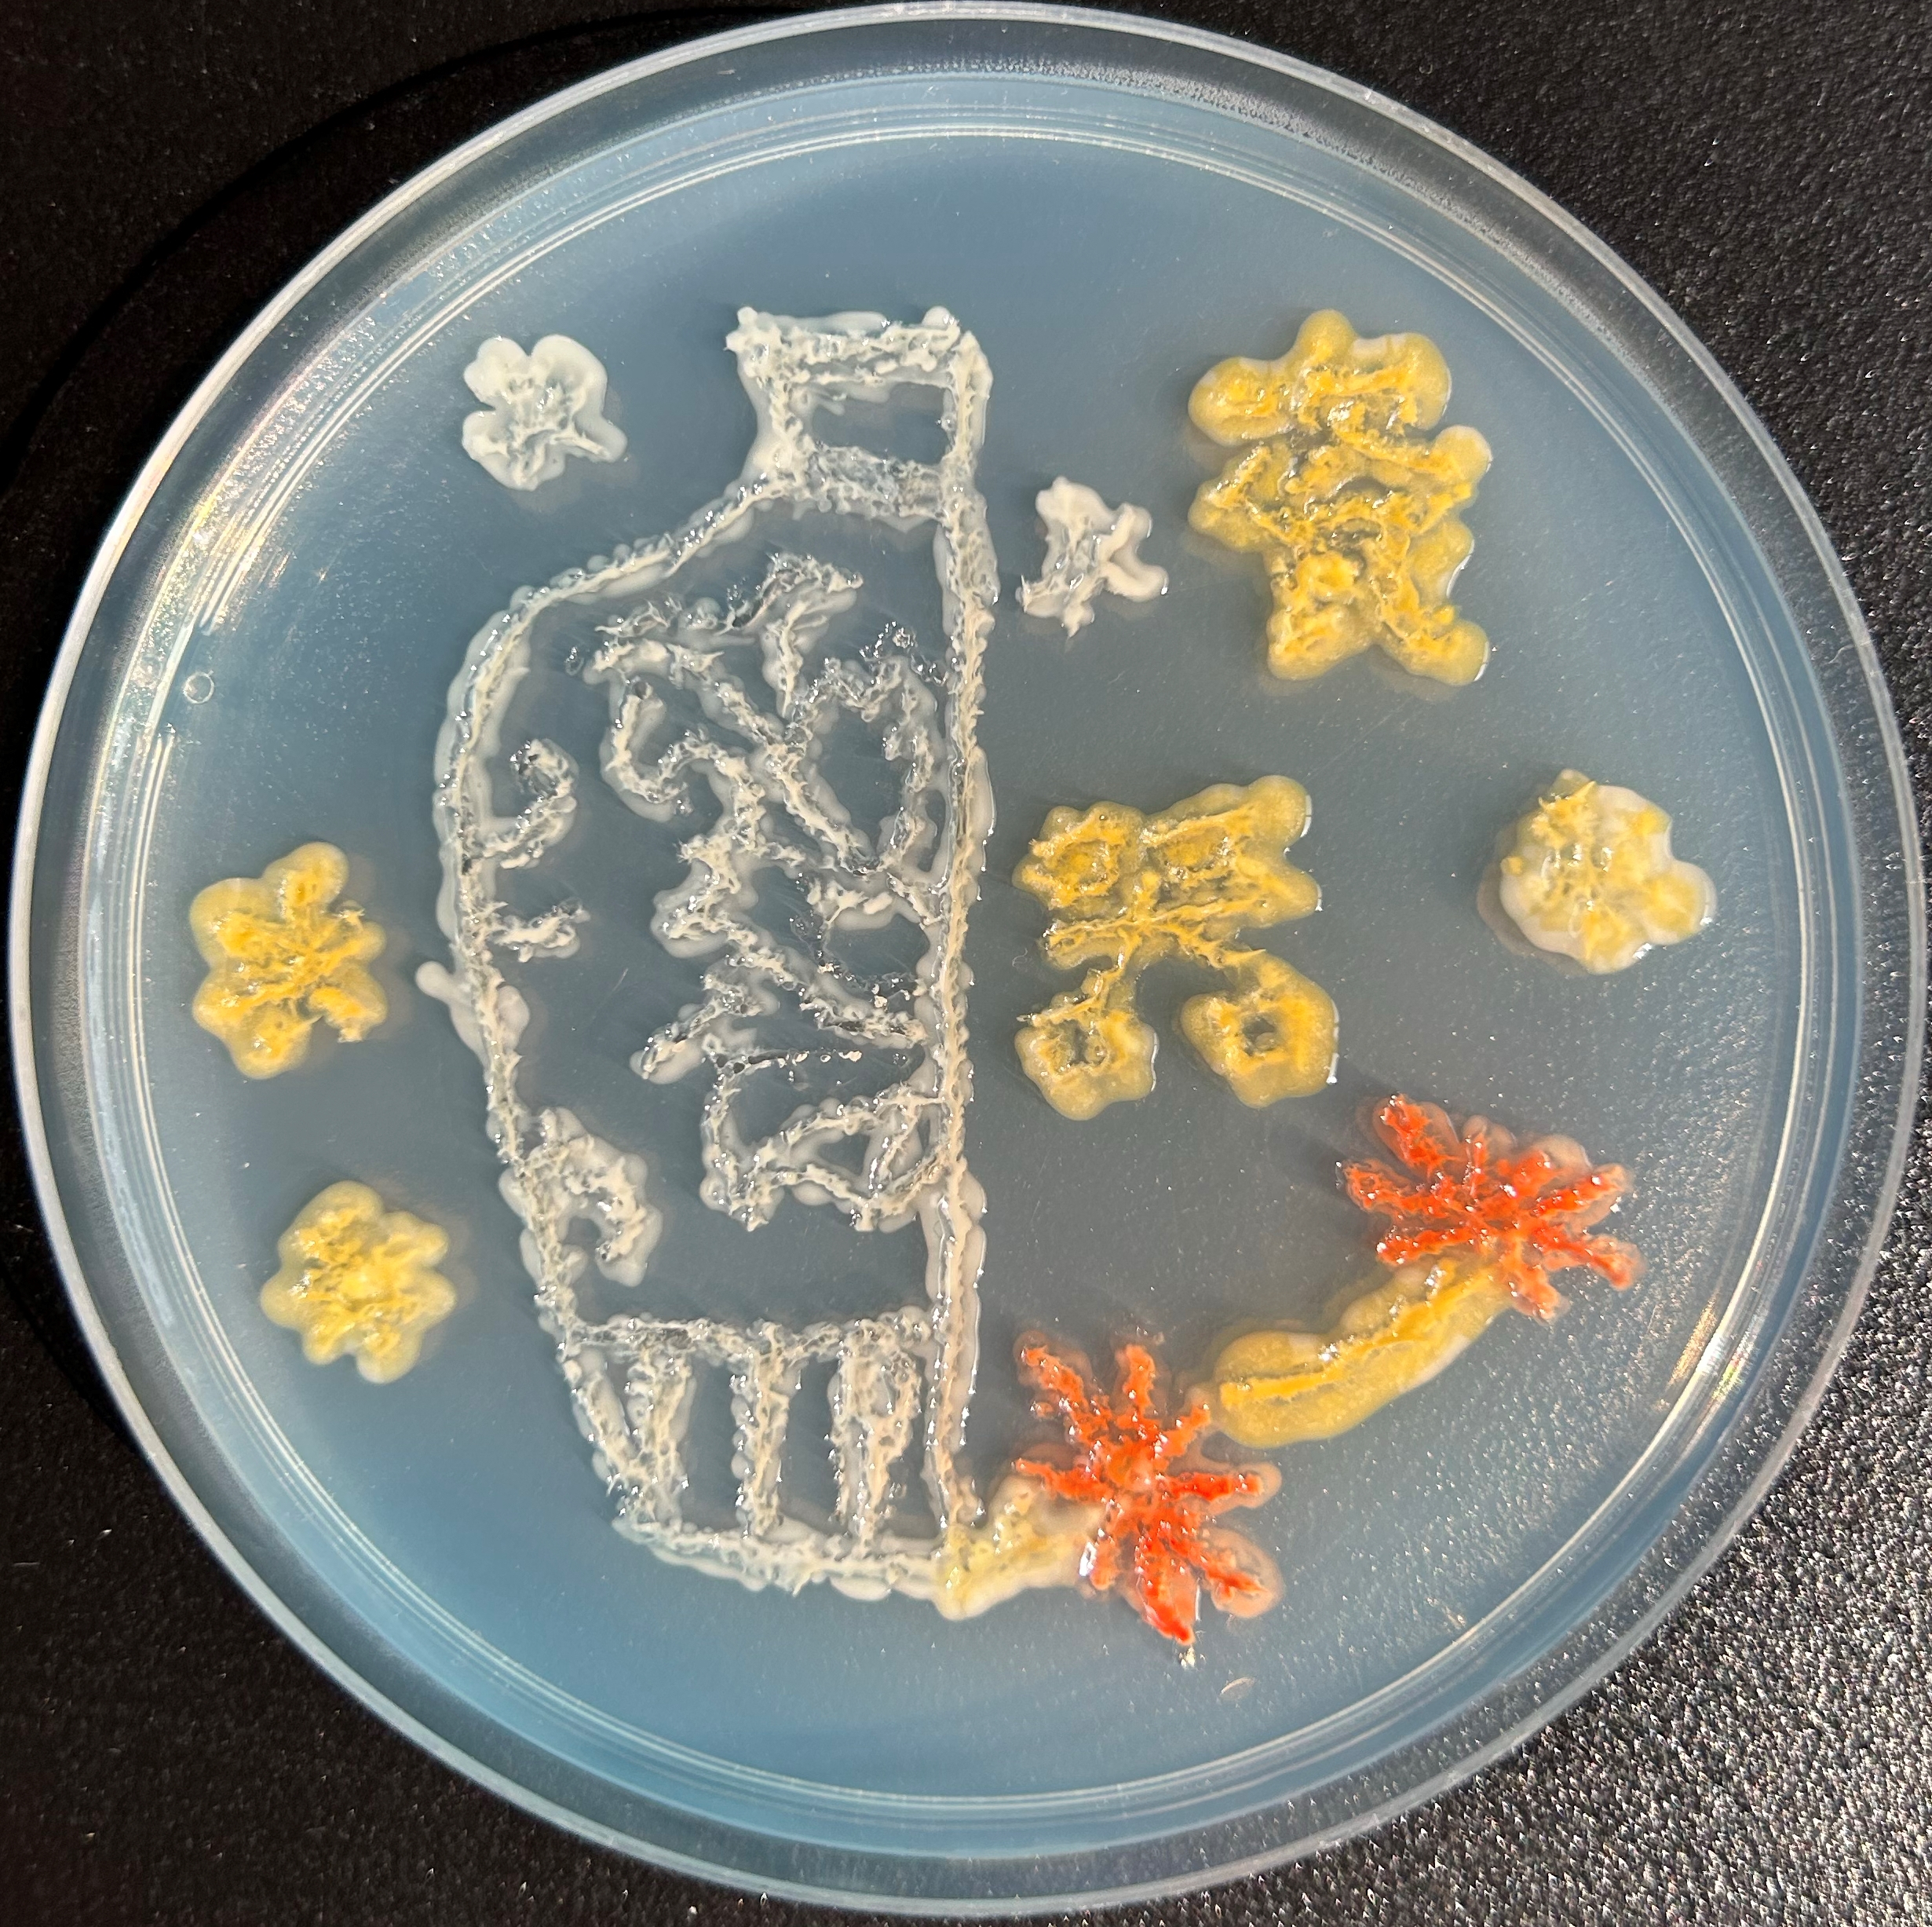
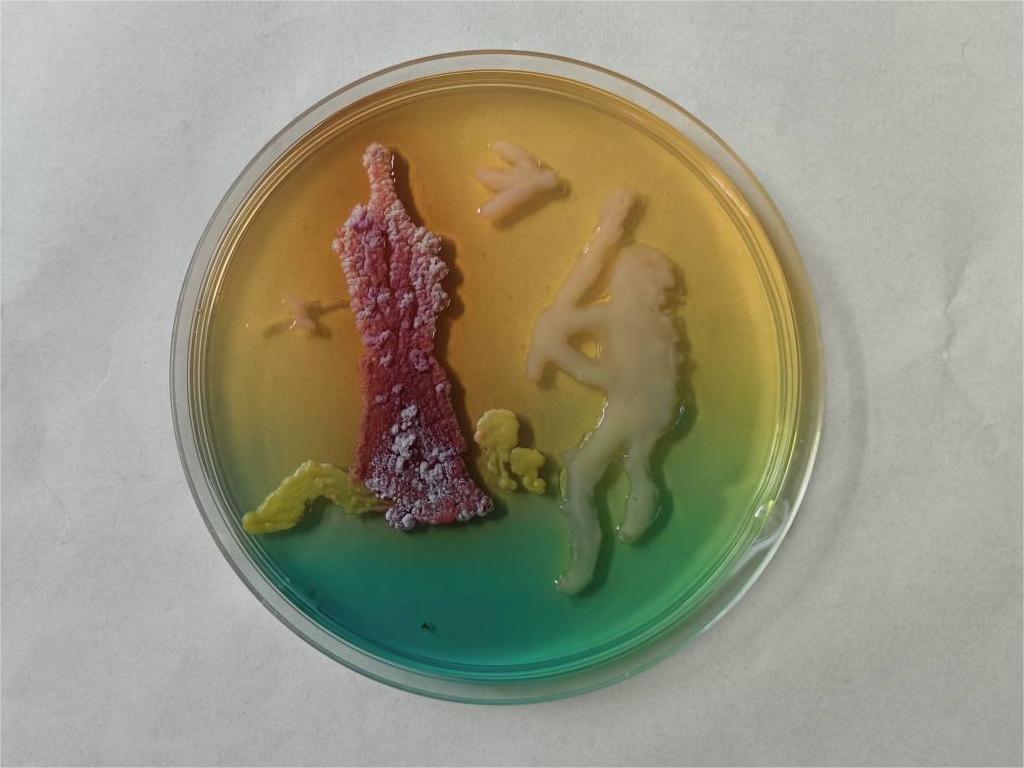

400-081-4789
400-081-4789Information Center
首頁 / 信息中心 / 行業新聞
時間:2023-12-12 來源:admin 點擊:2889次
第五屆“君立康杯” 微生物設計大賽圓滿結束,經過激烈的角逐,最終獲獎作品如下:


作品名稱:中國夢
參賽人員:張曉燦、許文婷
所屬學校:大連大學
指導教師:遲慶老師、孫慎俠老師
獲得獎項:特等獎

作品名稱:麒逾霄漢
參賽人員:刁赫、盧連生、王湘博
所屬學校:錦州醫科大學
指導教師:沈雁飛老師
獲得獎項:特等獎

作品名稱:錦繡山河詩意間
參賽人員:鄧佳洋、秦文潔、張婧超
所屬學校:遼東學院
指導教師:王旭老師、羅永成老師
獲得獎項:特等獎

作品名稱:煙雨江南
參賽人員:王巖松、王穎
所屬學校:遼東學院
指導教師:李娟老師
獲得獎項:特等獎

作品名稱:大國底蘊
參賽人員:代夢琦、趙雨涵、李宛頤、李易軒
所屬學校:沈陽藥科大學
指導教師:來琳琳老師、張怡軒老師
獲得獎項:特等獎

作品名稱:遙望麥稷知子春
參賽人員:王一博、鐘佳鑫、崔皓茗、許嘉洋
所屬學校:沈陽藥科大學
指導教師:陳羽老師、來琳琳老師
獲得獎項:特等獎


作品名稱:龍鳳呈祥
參賽人員:林青夏、王敏、何曉靚
所屬學校:大連大學
指導教師:遲慶老師、孫慎俠老師
獲得獎項:一等獎




作品名稱:大國重器
參賽人員:賀一真、張偉程
所屬學校:大連大學
指導教師:孫慎俠老師、鄭全老師
獲得獎項:一等獎




作品名稱:京劇臉譜
參賽人員:王茸、王浩丞
所屬學校:大連大學
指導教師:孫慎俠老師、遲慶老師
獲得獎項:一等獎

作品名稱:傳承
參賽人員:吳宇昕、楊小樂、李致娟
所屬學校:大連大學
指導教師:孫慎俠老師、遲慶老師
獲得獎項:一等獎

作品名稱:“氚”流不息
參賽人員:潘加彧、覃清松、王非凡、倪飛
所屬學校:大連海洋大學
指導教師:譚成玉老師
獲得獎項:一等獎

作品名稱:當當當當,瓦當中的文化符號
參賽人員:張璐、張藍月、關佳妍、朱曉曼
所屬學校:大連海洋大學
指導教師:孫曉東老師
獲得獎項:一等獎

作品名稱:漫天花開春意濃
參賽人員:宋雨欣、盧佳怡
所屬學校:遼東學院
指導教師:李娟老師
獲得獎項:一等獎

作品名稱:映日荷花別樣紅
參賽人員:武琳琳、楊智賢
所屬學校:遼東學院
指導教師:王旭老師、羅永成老師
獲得獎項:一等獎

作品名稱:芙蓉花開愜靜池
參賽人員:張陽、孫芳琪
所屬學校:遼東學院
指導教師:王旭老師、楊平老師
獲得獎項:一等獎




作品名稱:皿中神獸
參賽人員:趙子茹、宋金書、王麗鑫、時蕊蕊
所屬學校:遼寧工程技術大學
指導教師:王麗威老師
獲得獎項:一等獎

作品名稱:梅蘭竹菊
參賽人員:陳華豫、張博源、楊思寧、趙婧婷
所屬學校:遼寧何氏醫學院
指導教師:韓旭老師、郭滿厚老師
獲得獎項:一等獎

作品名稱:十二生肖
參賽人員:閆智峰、汪雯馨、解勝雪、單鴻博
所屬學校:遼寧何氏醫學院
指導教師:韓旭老師、駱玲老師
獲得獎項:一等獎



作品名稱:無指境
參賽人員:昭娜、郝梓辰、楊冬伶
所屬學校:沈陽城市建設學院
指導教師:丁蕊老師、馬哲老師
獲得獎項:一等獎

作品名稱:幽蘭
參賽人員:張堯、姜泊宇、胡洋、劉俊良
所屬學校:沈陽城市學院
指導教師:譚艷妮老師、范銘老師
獲得獎項:一等獎

作品名稱:青春&運動&熱愛
參賽人員:李穎棽、符馨月、王庭宇
所屬學校:沈陽工學院
指導教師:曹輝老師
獲得獎項:一等獎

作品名稱:紅日照征途
參賽人員:田文慧、包子欣
所屬學校:沈陽化工大學
指導教師:岳靜老師
獲得獎項:一等獎



作品名稱:大好河山
參賽人員:岳明珠、郭旭、李盼
所屬學校:沈陽農業大學
指導教師:高嵩老師
獲得獎項:一等獎

作品名稱:古器龍鳳紋
參賽人員:陳奕融、麻越、韓宣、智尹珊
所屬學校:沈陽藥科大學
指導教師:武昕老師、金汝天老師
獲得獎項:一等獎

作品名稱:盛世杭州 美好亞運
參賽人員:汪琦、喻婷、蘇宇鑫
所屬學校:沈陽藥科大學
指導教師:生陽老師、吳瑩瑩老師
獲得獎項:一等獎




作品名稱:文源閔來
參賽人員:呂泓霏、鄧赫
所屬學校:沈陽藥科大學
指導教師:程娟老師、吳瑩瑩老師
獲得獎項:一等獎